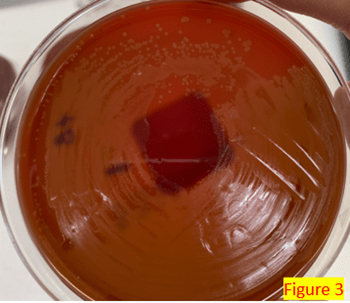

Case Presentation
Patient is a 45 year old Vietnamese male who presented initially to the Emergency Room with altered mental status at home. Patient presented with hypotension and hypothermia and was admitted to the ICU. Past medical history is significant for HIV although the patient has not be on antiretroviral therapy (ART), syphilis, and active Pneumocystis infection. His CD4 count was 15 on arrival, and he was placed on multiple prophylactics for prevention of opportunistic infections. Blood and cerebrospinal fluid (CSF) were submitted for cultures. Encapsulated yeast were seen on the CSF which was positive for Cryptococcus neoformans on a rapid multiplex-PCR panel (BioFire Film Array Meningitis/Encephalitis panel) followed by isolation of the yeast in culture and identification using the MALDI-TOF. Yeast was also found in the blood cultures, also identified as Cryptococcus using a rapid blood culture identification panel (BioFire Film Array Blood Culture Identification Panel 2.0) which subsequently grew out C. neoformans, also identified using MALDI-TOF.
Discussion
Cryptococcus species areencapsulated yeast cells with a natural habitat in the soil. Promotion of organism replication happens in alkaline pH environments with higher nitrogen concentrations. For example, soil contaminated with turkey, chicken, bat, or pigeon droppings can contribute to this growing environment. Yeast cells can become airborne with soil disruption, and contribute to increased risk of infection to immunocompromised hosts with certain activities. Aside from pulmonary infections, meningoencephalitis is another common manifestation of infection.1 Patients may have neurological deficits and increased intracranial pressure. A wide spectrum of symptoms have been reported including fever, malaise, headache, neck stiffness, photophobia, nausea, vomiting and sometimes rarely a cough, dyspnea, and skin rashes. Generally speaking, Cryptococcus neoformans is usually associated with infections in immunocompromised patients while Cryptococcus gatti is associated with infections in immunocompetent patients.2 Positive blood cultures with Cryptococcus is typically representative of disseminated infection.
The major virulence factor is the capsule which plays a role in preventing phagocytosis and providing an adherence mechanism to mucosal linings. Not all strains produce capsules, but the colony on growth medium could be mucoid (image 1). The capsules of Cryptococcus may group to one another, almost forming a ‘honeycomb’ matrix with the polysaccharide capsule separating the forms from each other. Additionally, Cryptococcus produce a melanin pigment, which is considered a virulence factor because it protects the yeast from oxidant-induced stressors. As such, the Fontana-Masson stain used in histopathology will be positive due to the melanin production of the organism. Cryptococcus neoformans is responsible for most human infections, and Cryptocococcal infections are considered to be opportunistic, with immunocompromised populations being at highest risk.3

Microscopically, Cryptococcus is an irregularly sized (4-10µm), round, encapsulated yeast. It can also appear as a budding yeast.3 Direct staining of the CSF specimen can be done using India ink which will form a “halo” around the yeast cells as the ink stains the capsule. Cream-colored, sometimes mucoid, colonies will appear in agar plates in 3-7 days. Aside from PCR and MALDI-TOF, differentiation between Cryptococcal neoformans and Cryptococcal gatti can be possible using canavanine, glycine, bromothymol blue agar. Growth of Cryptococcus gatti will turn the agar blue. Detection of cryptococcal antigen through immunodiagnostic tests of the serum and the cerebrospinal fluid can also provide a diagnosis of the infection. CSF parameters of infected individuals typically show low white blood cell count, low glucose, and elevated protein but up to 30% of the cases have also reported normal CSF parameters.4 Histopathology staining using mucicarmine is specific for the presence of Cryptococcus. Radiograph imaging of the brain have also been shown to be helpful.
Rapid detection of Cryptococcal infections and other opportunistic infections are imperative to improving patient outcomes. Mortality from cryptococcal meningitis in the “meningitis belt” of Sub-Saharan Africa approaches 75%, with an 89% incidence rate.5 A combination of factors including higher HIV carriage rate, lack of available preventative care, and dry seasons with dry winds and cold nights lend to this region’s higher incidence rates. Moreover, lack of cheaper and reliable testing methods for detection and possible initiation of prophylactic medications are contributors of higher mortality rate. Recent studies investigate how the efficacy of rapid antigen assays like lateral flow assays might have a role in filling some of these care gaps in an efficient and cost-effective way, but further study is required.5 Mainstays of treatment for cryptococcal infections include amphotericin B, flucytosine, and fluconazole.2 Monitoring intracranial pressure and keeping it under check plays an important role in reducing the mortality associated with cryptococcal meningitis.6 Lumbar puncture is the recommended option for management of intracranial pressure and either a ventricular drain or ventricular peritoneal shunt is used in patients who require frequent lumbar punctures.
References
- Park BJ, Wannemuehler KA, Marston BJ, Govender N, Pappas PG, Chiller TM. Estimation of the current global burden of cryptococcal meningitis among persons living with HIV/AIDS. AIDS. 2009 Feb 20;23(4):525-30.
- Cox, Gary M, Perfect, John R. Cryptococcus neoformans meningoencephalitis in patients with HIV: Treatment and prevention. June 9, 2021, UptoDate. https://www.uptodate.com/contents/cryptococcus-neoformans-meningoencephalitis-in-patients-with-hiv-treatment-and-prevention?search=cryptococcal%20meningitis%20treatment&source=search_result&selectedTitle=1~83&usage_type=default&display_rank=1. Accessed 10/7/2022
- Winn, Washington C. Jr. et al. Koneman’s Color Atlas and Textbook of Diagnostic Microbiology, 6th Edition. 2006. Lippincott Williams and Wilkins.
- Garlipp CR, Rossi CL, Bottini PV. Cerebrospinal fluid profiles in acquired immunodeficiency syndrome with and without neurocryptococcosis. Rev Inst Med Trop Sao Paulo. 1997 Nov-Dec;39(6):323-5.
- Okolie CE, Essien UC. Optimizing Laboratory Diagnostic Services for Infectious Meningitis in the Meningitis Belt of sub-Saharan Africa. ACS Infect Dis. 2019 Dec 13;5(12):1980-1986. doi: 10.1021/acsinfecdis.9b00340. Epub 2019 Nov 18. PMID: 31738509.
- Rolfes MA, Hullsiek KH, Rhein J, Nabeta HW, Taseera K, Schutz C, Musubire A, Rajasingham R, Williams DA, Thienemann F, Muzoora C, Meintjes G, Meya DB, Boulware DR. The effect of therapeutic lumbar punctures on acute mortality from cryptococcal meningitis. Clin Infect Dis. 2014 Dec 01;59(11):1607-14.

-Dr. Katelyn Swanson is a currently a PGY-1 pathology resident at George Washington University. She completed a clinical laboratory science program at Franciscan Health in Indianapolis, IN, and received her MLS (ASCP) certification before attending and graduating medical school from Lake Erie College of Osteopathic Medicine at Seton Hill. She completed a transitional year internship at Walter Reed National Military Medical Center and one General Medical Officer billet with the Navy before starting pathology residency. She is still exploring her research interests.

-Rebecca Yee, PhD, D(ABMM), M(ASCP)CM is the Chief of Microbiology, Director of Clinical Microbiology and Molecular Microbiology Laboratory at the George Washington University Hospital. Her interests include bacteriology, antimicrobial resistance, and development of infectious disease diagnostics.